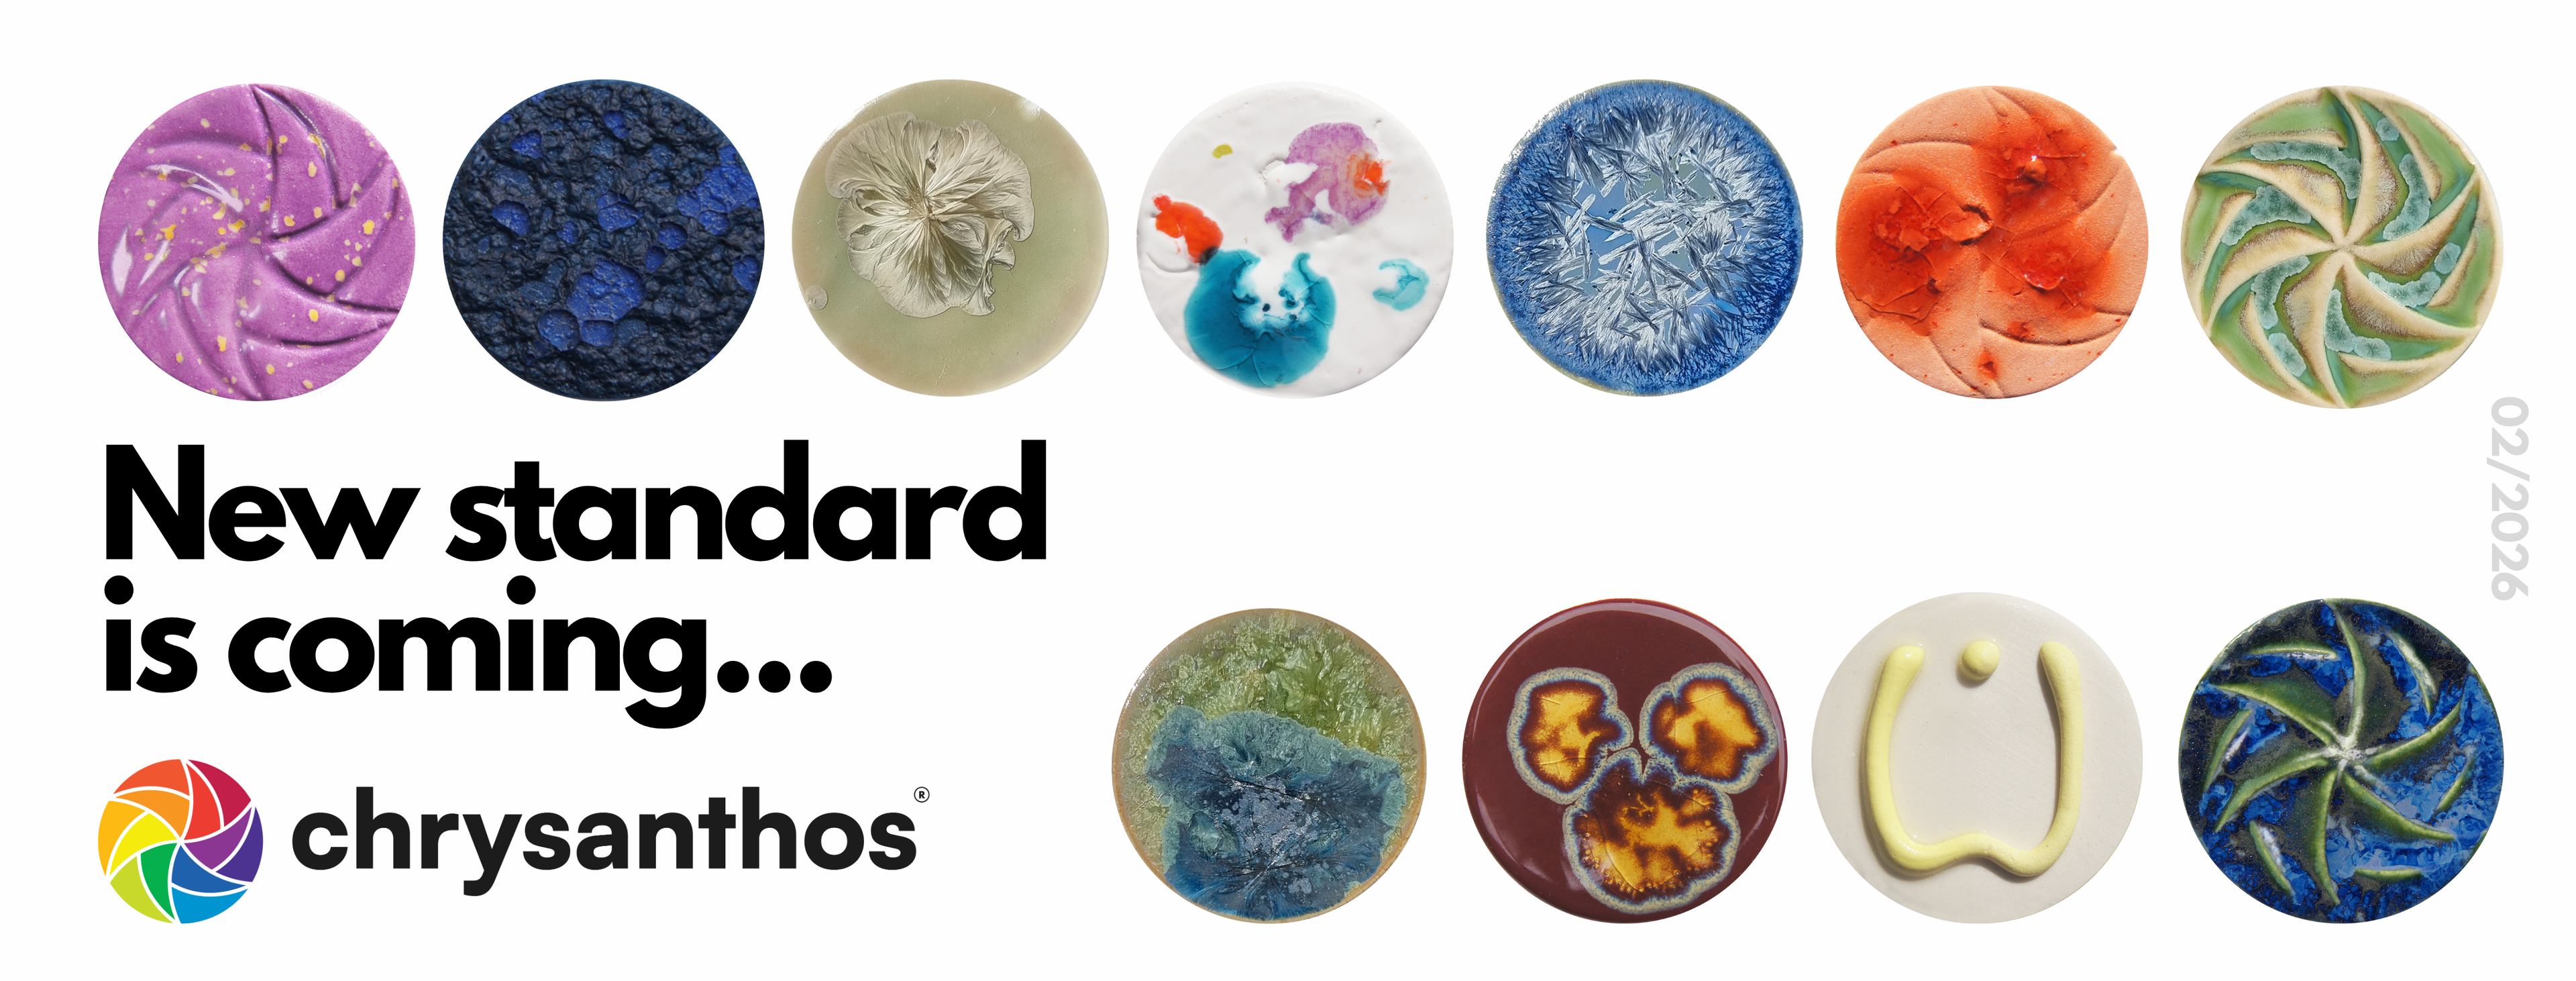

Ceramiq.pl – sklep i szkoła ceramiki dla pasjonatów sztuki
Repeatable effects
Worried about surprises after firing? We've got you covered! Our experts test and select materials for consistent results.
Ready to use
Running workshops? Our glazes and paints minimize preparation. Open and create immediately!
Your matching sets
Unsure what to choose for modeling? Our ready-made kits with compatible clay and glaze will save you valuable time!
Materials always on time
Concerned about delays? We understand! We ship the same day you order or the next business day.
Discover what's new at Ceramiq.pro
Mayco STONEWARE GLAZES "Pink Pearl" 473 ml
Mayco STONEWARE GLAZES "Tidal Wave" 473 ml
Liquid porcelain TWIST - Mustard 5kg
Liquid porcelain TWIST - Gemlik 5kg
Liquid porcelain TWIST - Foca 5kg
Mayco STONEWARE GLAZES "Lilac Speck" 473 ml
Mayco STONEWARE GLAZES "Pink Speck" 473 ml
Mayco STONEWARE GLAZES "Baby Blue Speck" 473 ml
Plastic Porcelain SIO2 Begur Rose 5 kg
Liquid Porcelain TWIST - Titus 5kg
HIGH FIRE GLAZE BRIGHT BLUE 140 ml
SUPERNOVA GLAZE MIRA 140 ml
VOLCANO GLAZE ARENAL 140 ml
STONEWARE EXOTIC POMEGRANATE 140 ml
3D THIN TRAIL GLAZE H BLUE 60 ml
CRYSTALLITE TERRACOTTA 140 ml
STONEWARE GLAZE PRISM RED 140 ml
STONEWARE EXOTIC MARBLE BROWN 140 ml
FANTASY GLAZE H LADY BIRD 140 ml
STONEWARE EXOTIC SEA AGATE 140 ml
MATT GLAZE H VIOLET 140 ml
HIGH FIRE GLAZE TORO RED 140 ml
FANTASY GLAZE H DALMATION 140 ml
HIGH FIRE EXOTIC SODALITE 140 ml


About Us
Ceramiq.pro – simple solutions for your studio. Do you run a ceramics studio, workshop, or teach at a school? You know that the most time-consuming part isn't the creation itself, but the preparation: measuring powders, searching for materials, waiting for deliveries. That's why Ceramiq.pro was created – a store with proven, ready-to-use materials. We're not just "another online store." We're part of Ceramiq – a brand that has been supporting ceramicists for years and runs its own school. This allows us to understand the real needs of studios and offer solutions that truly make work easier.
About usBestsellers
Most frequently chosen by ceramists
Ceramiq Viral Glaze Redcurrant
Liquid overglaze gold 10% - 5 grams
Ceramiq Viral Glaze Drozd Spiewak
Ceramiq Viral Glaze Quail
Wooden Scraper R17 "macgyver L"
Ceramiq Viral Glaze Green Dragon
Ceramiq Viral Glaze Sun Crater
Ceramiq Viral Glaze Speckled Sandstone
Ceramiq Viral Glaze Fire Salamander
Dadya ceramic glaze SP1518 118 ml
R8 "Kingsize" Wooden Scraper
Mayco Specialty Glazes "Light Magma" 473 ml
Ceramiq Viral Glaze Mint Ice Cream
Clay SiO2 PRAI White 40% 0-0.2 mm fireclay - 12.5 kg
Turquoise Green ceramic glaze S1020 118 ml
Goerg & Schneider Clay No. 254 - white 10 kg
Ceramiq Viral Glaze Stracciatella
SiO2 Luna Clay - 12.5 kg
Ceramiq Viral Engobe Blue
SiO2 PB clay classic, white - 12.5 kg pack
Mayco Jungle Gems “Blueberry Bubblegum” 118 ml
Botz Pro 9313 White Pyrite Liquid Glaze - 200 ml
Sibelco clay No. WM 2502 - light, 10 kg
Ceramiq Viral Glaze Arctic
Botz 9608 Harlekin Liquid Glaze - 200 ml
Producers